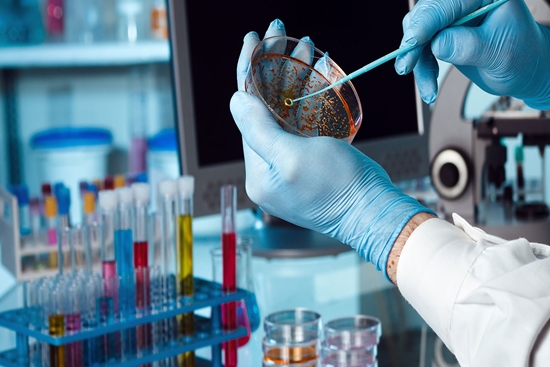

دکتر زالی:
70 درصد تشخیصهای پزشکی از دالان علوم آزمایشگاهی میگذرد
رییس دانشگاه علوم پزشکی شهید بهشتی در افتتاحیه کنگره بینالمللی ارتقای کیفیت خدمات آزمایشگاهی گفت: بالغ بر 70 درصد تشخیصها در حوزه پزشکی از دالان علوم آزمایشگاهی میگذرد.
به گزارش روابط عمومی دانشگاه علوم پزشکی شهید بهشتی، دکتر علیرضا زالی در افتتاحیه پانزدهمین کنگره بینالمللی و بیست و یکمین کنگره کشوری ارتقای کیفیت خدمات آزمایشگاهی تشخیص پزشکی ایران که صبح امروز در مرکز همایشهای برج میلاد برگزار شد، همکاران علوم آزمایشگاهی را پیشقراولان نهادینهسازی کیفیت ارایه خدمات سلامت دانست و گفت: مفهوم کیفیت، وامدار کارشناسان و متخصصان علوم آزمایشگاهی است. هیچ بخشی از نظام سلامت به میزان علوم آزمایشگاهی پایبندی به حوزه کیفیت را تجربه نکرده است.
وی با اشاره به اینکه کمتر دانشجوی علوم آزمایشگاهی است که به شاخصهای کیفی این رشته آشنا نباشد، گفت: از سال 1386 که شاخص ISO 15189 وارد مجموعه مدیریتی و نظارتی آزمایشگاهها شد که هر دو مولفه مدیریتی و تکنیکال در آن ممزوج است. توجه سیستماتیک فرآیند محور به اصول کیفیت با نگاه سامانگر متخصصان ازمایشگاهی، تضمین کیفیت در این حوزه را به همراه دارد.
رییس دانشگاه با تاکید بر جایگاه انکارناپذیر علوم آزمایشگاهی در نظام سلامت، تصریح کرد: در کالبد سلامت پیاده سازی اصولی هیچ جزئی اعم از تشخیص، پیشگیری، غربالگری، درمان، پیگیری و رصد اجتماعی بدون علوم آزمایشگاهی محقق نخواهد شد.
دکتر زالی ادامه داد: در سالهای اخیر وابستگی به علوم آزمایشگاهی با وجوه متنوعتر و جذابتری همراه شده است.
وی گفت: علوم آزمایشگاهی از حرفههایی است که سند مستند و قابل ارجاع در اختیار مراجعه کننده و بیمار قرار میدهد. این سند افتخارآمیز، پیامدی است که خروجی تلاشها، کیفیت سنجی و اصالت کاری کارشناسان و متخصصان را نشان میدهد.
دکتر زالی برای درک بهتر نقش علوم آزمایشگاهی در نظام سلامت، عنوان کرد: در حال حاضر شش هزار آزمایشگاه تشخیص طبی در عرصه سلامت مشغول به فعالیت هستند که از این تعداد 2 هزار و 300 آزمایشگاه توسط بخش خصوصی اداره می شود.
وی از انجام سالانه بیش از 2 میلیارد آزمایش با حداقل خطا در سطح کشور خبر داد و گفت: همکاران علوم آزمایشگاهی علیرغم تمام سختیها و خسارتهای اقتصادی، همواره با نظام سلامت همراه بودند.

رییس دانشگاه در ادامه بر اهمیت بهروز بودن دانش فراگیران، کارشناسان و متخصصان تاکید کرد و گفت: جهان پزشکی امروز در آستانه تحول بزرگی است، در همین راستا همکاران علوم آزمایشگاهی باید آماده دگردیسی جسورانه برای انطباق با یافتههای نوین آزمایشگاهی باشند.
وی تصریح کرد: لزوم بهرهگیری از ظرفیت هوش مصنوعی نباید نادیده گرفته شود، چراکه قدرت یادگیری این ابزار میتواند نقش مهمی در گرفتن نمونه، آنالیز کردن، کیفیت سنجی و تشخیص دقیق ایفا کند. علوم آزمایشگاهی باید در مسیر پزشکی فرادقیق و پزشکی فردمحور گام بردارد تا در شکاف علم روز غرق نشود.
وی در پایان گفت: در عین افتخار به خدمترسانیهای میهن دوستانه همکاران علوم آزمایشگاهی در روزهای سخت، در مسیر نوآوری و فناوریهای نوین باید شتابان حرکت کرد.
نقش محوری آزمایشگاهها در نظام سلامت
دکتر شهروز همتی دبیر علمی پانزدهمین کنگره بین المللی و بیست و یکمین کنگره کشوری ارتقای کیفیت خدمات آزمایشگاهی تشخیص پزشکی ایران در حاشیه برگزاری این کنگره اظهار کرد: کنگره امسال از ۱۱ تا ۱۴ اردیبهشت ۱۴۰۳ در سالن همایش های برج میلاد برگزار میشود که در این کنگره، ۲۵ محور علمی وجود دارد و ۴۵ کارگاه آموزشی برگزار خواهد شد.
وی افزود: در این کنگره و در بخش نمایشگاهی، بیش از ۲۰۰ شرکت تولید کننده و دانش بنیان حضور دارند.
دکتر همتی ادامه داد: هرسال کنگره یک رویکرد اصلی دارد و در سنوات گذشته رویکرد اصلی کنگره کرونا و هوش مصنوعی بوده است اما امسال نقش ومحوری کنگره، نقش آزمایشگاهها در نظام سلامت است.
وی ادامه داد: مطالب علمی در کارگاهها براساس نیازسنجی ها ارایه میشود و پیش بینی می شود ۸ هزار نفر از کنگره امسال بازدید کنند و ۳۵۰۰ نفر تاکنون در بخش علمی ثبت نام کرده اند که نسبت به سال گذشته افزایش مخاطب شاهد هستیم.
انتهای پیام/
کد خبرنگار: 7702 ی.ق
